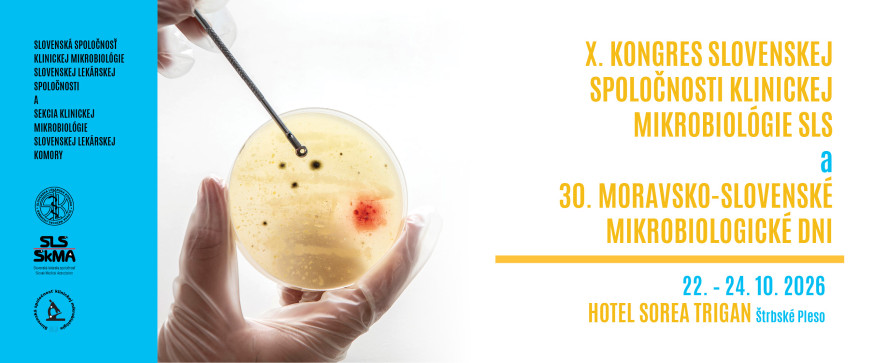
web | X. kongres Slovenskej spoločnosti klinickej mikrobiológie SLS  a  30. Moravsko-slovenské mikrobiologické dni

MUDr. Miroslava Horniačková, PhD., MPH
MUDr. Zuzana Kónyová
RNDr. Jaroslav Bojňanský
Mgr. Eva Krejčí, PhD.
MUDr. Zuzana Bečková, PhD.
RNDr. Vojtech Boldiš, PhD.
MUDr. Monika Czirfuszová, PhD.
doc. RNDr. Lívia Slobodníková, PhD.
MUDr. Rudolf Botek
doc. MUDr. Milan Nikš, CSc.
prof. RNDr. František Ondriska, CSc.
MUDr. Emília Miková
prof. MUDr. Adriána Liptáková, PhD.
Sekcia klinickej mikrobiológie SLK
-
Metagenomika a klinická mikrobiológia
-
Multiplexové PCR v klinickej mikrobiológii
-
Infekcie krvného prúdu, hemokultivačné metódy
-
Antimikrobiálna rezistencia, testovanie citlivosti a antimikrobiálne stewardship
-
Infekcie močového systému
-
Infekcie preventabilné očkovaním
-
Novinky vo virológii
-
Varia